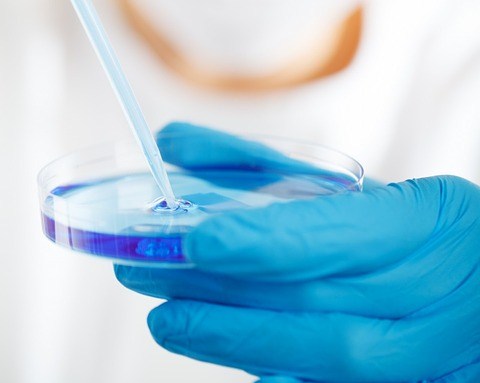
laboratorio

NOVARA -01-06-2019 - Anche la città
di Novara vuole cercare di aiutare il piccolo Gabriele, un bimbo di Milano di 19 mesi affetto da una rara malattia per il quale è necessario trovare un donatore compatibile di midollo osseo. Oggi pomeriggio, sabato 1° giugno, dalle 14, volontari Admo, Ugi e Polisportiva San Giacomo, saranno in via Fratelli Rosselli per aiutare a trovare il donatore. La compatibilità sarà verificata con un semplice prelievo della saliva, che può essere fatto da persone in buona salute di età compresa fra 18 e 35 anni e del peso di almeno 50 kg.


